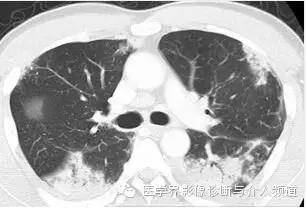
【病例】嗜酸粒细胞性肺炎1例X线CT影像表现 【病例】嗜酸粒细胞性肺炎1例X线CT影像表现

【病例】嗜酸粒细胞性肺炎1例X线CT影像表现
发布时间:2022-10-22
发布时间:2022-10-22
【临床资料】
男,54岁,发烧咳嗽2周。
【影像图像】
初始胸片

初始CT

随访胸片

【影像表现】
初始胸片示两肺野多灶性斑片影,其中两肺上野靠近外周可见边界欠清的实变影,这是典型的慢性嗜酸性粒细胞性肺炎“肺水肿反转影”的表现。CT示两肺叶多灶性非节段性实变影,病变以两上肺周围性分布为主。
———-♀【病例讲堂】分割线♀———
小编留言:这些患者是别人的,但这些症状你工作中也可能会遇到,学习才是前进的唯一路径,有思考才有进步哦!
【最终诊断】
慢性嗜酸粒细胞性肺炎
【鉴别诊断】
急性嗜酸性粒细胞肺炎(AEP)
AEP起病急骤,有1周以内的急性发热;CT 片示,双肺弥漫性浸润阴影;可有较重的低氧血症,肺泡灌沅液(BALF)嗜酸性粒细胞≧25%或肺活检示嗜酸性粒细胞弥漫性浸润,但外周血嗜酸性粒细胞正常;无支气管哮喘或过敏史;能自愈或糖皮质激素治疗有效;愈后无复发。
Loffler综合征
病因未明,CT表现为一过性、游走性嗜酸性粒细胞炎性斑片状渗出影,外周血嗜酸性粒细胞多升高,临床症状轻微,为自限性疾病,多不需治疗,一般在 1~2周内自愈。
肺结核
依据典型肺结核及薄壁空洞影像学表现,容易鉴别。
周围型肺癌
CT示肿块密度多欠均匀,可见偏心性空洞,壁厚薄不均,常为分叶状,肿块边缘有毛刺及胸膜凹陷征,不典型者穿刺活检可鉴别。
热带嗜酸性粒细胞增多症
有丝虫病流行区生活史,临床表现为发热、阵发性咳嗽和呼吸困难,肺部可闻及哮鸣音。CT片示肺有渗出影,血嗜酸性粒细胞增多,血丝虫补体结合试验阳性。
【影像学表现】
影像学检查在CEP诊断中有重要的作用,CT或HRCT检查能更准确地显示肺内病变的部位,特别是临床怀疑而普通X线胸片表现不典型的病例。
CEP的典型影像学表现:普通X线平片为非节段性、分布广泛互相融合的肺泡及间质性实变,病变以中上肺周围性分布为主,表现为“肺水肿反转影”。CT或HRCT表现为一侧或两侧融合性实变、斑片状实变、磨玻璃影、条带状致密影,实变灶与正常肺组织的分界截然清楚。此种典型征象并非见于所有CEP病例。
嗜酸性肺病病因复杂,临床表现及影像学改变又相互重叠,而慢性嗜酸性肺炎的影像学改变相对有一定的特征性,通过胸部X线片及CT检查显示有特征性的肺实质异常及分布,配合血液、支气管肺泡灌洗液或组织内嗜酸性细胞的增加,可提高临床诊断水平。
上一篇:经典影像征解析之呼吸篇